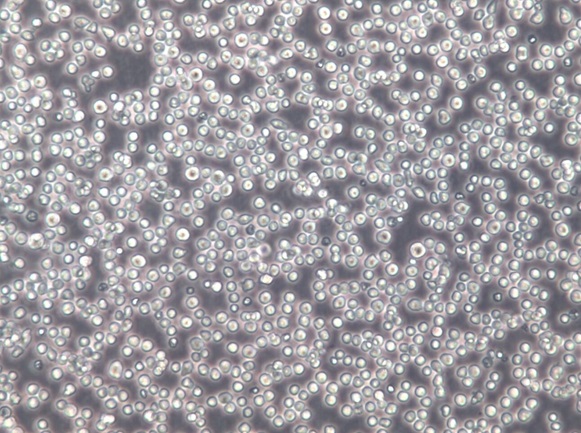

Your present position: Home > 产品中心 147
SU-DHL-8;人B细胞淋巴瘤细胞【已通过STR鉴定】
Product Introduction
目录号 |
CC-Y1844 |
细胞英文(简称) |
SU-DHL-8 |
细胞名称 |
SU-DHL-8;人B细胞淋巴瘤细胞【已通过STR鉴定】 |
背景资料 |
SU-DHL-8是一种B淋巴细胞系,于1978年从一名59岁的白人男性大细胞淋巴瘤患者的淋巴结中分离出来。 |
细胞来源 |
ATCC |
代次 |
P3 |
规格 |
T25 |
细胞数 |
1x10^6 |
价格 |
¥2480 |
生物安全级别 |
1 |
组织来源 |
淋巴瘤 |
细胞形态 |
淋巴母细胞样 |
细胞活力 |
95%(Viability by Trypan Blue Exclusion) |
细胞检测 |
细胞不含有HIV-1、HBV、HCV、支原体、细菌、酵母和真菌 |
培养条件 |
RPMI-1640+10% FBS(货号:C2056-1A)+1%P/S;37℃,5% CO2 |
传代方法 |
首次建议1:2传代,两天换液一次 |
冻存条件 |
无血清细胞冻存液(货号:S002) |
